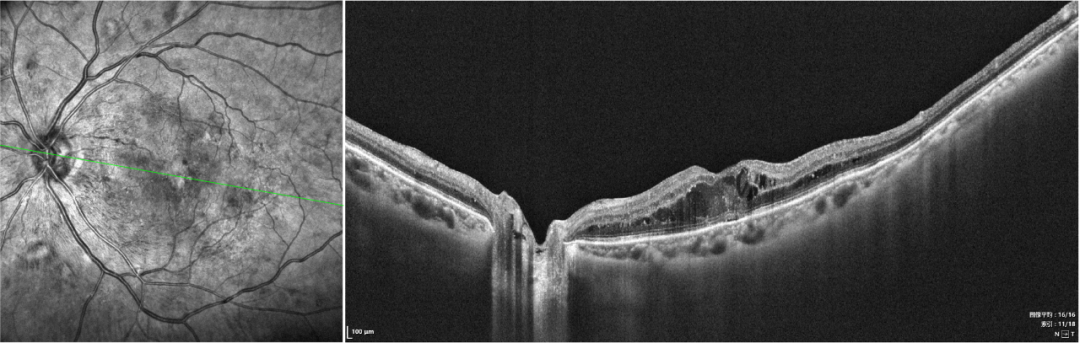
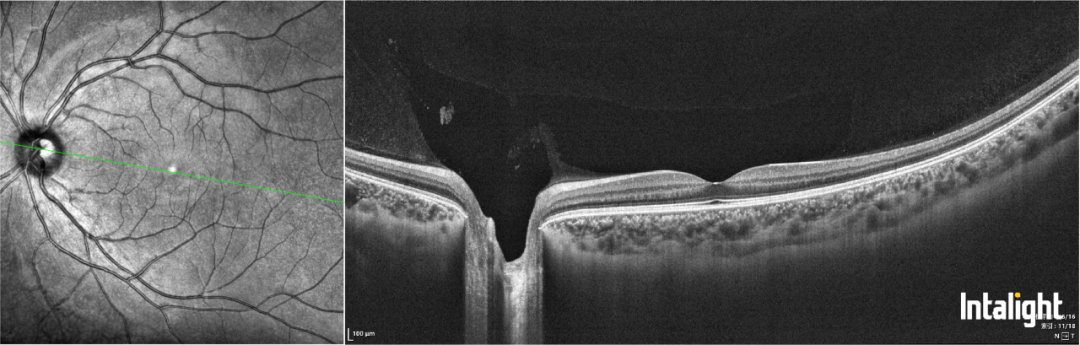

近期,四川大学华西第二医院眼科团队在国际知名期刊《Drug Design, Development and Therapy》上发表了题为《糖尿病黄斑水肿的药物治疗:2025年关于疗效持久性与多靶点疗法的更新》的综述文章。该文章系统梳理了糖尿病黄斑水肿(DME)治疗领域的最新进展,为临床实践提供了前沿的学术参考。据了解,目前该文章已被国际权威数据库Web of Science收录。

《Drug Design, Development and Therapy》是一本由Dove Medical Press出版的开放获取、同行评议的国际性期刊,专注于药物设计、开发到临床应用的完整链条。根据最新数据,该期刊2024-2025年最新影响因子为5.1,五年影响因子为5.2,在JCR(Journal Citation Reports)分区中位于Q1区,在中科院期刊分区中属于医学大类2区,在药学与药物化学领域具有较高的学术声誉。
糖尿病黄斑水肿oct图像
正常眼底黄斑oct图像
糖尿病视网膜病变是重要的致盲性眼病,而糖尿病黄斑水肿(DME)是导致患者视力损害的核心环节。传统疗法虽有效,但仍面临治疗频率高、部分患者效果不佳等挑战。华西二院眼科团队的这篇综述文章,核心在于系统阐释了当前DME治疗领域两个清晰的趋势:一是从追求单次最佳疗效转向追求长期疗效的持久性,以减轻患者频繁就医的负担;二是从针对单一靶点转向探索多通路协同干预的策略,旨在为不同情况的患者提供更有效的治疗方案,这些进展标志着DME的管理正迈向一个更注重长期疗效、安全性与功能结果的精准医学框架。

近年来,科室在持续夯实妇幼眼科特色的同时,服务范围正稳步向“全眼疾覆盖”延伸。此次在糖尿病视网膜病变这一重大致盲性眼病领域发表高水平国际综述,展现了团队将扎实的临床积累与国际化学术视野相结合的能力。同时,也是科室综合诊疗能力持续提升、全年龄段眼病诊疗体系不断完善的重要体现。
 华西第二医院
华西第二医院





